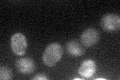
YDL246C

View description
Protein of unknown function; protein sequence is 99% identical to the Sor1p sorbitol dehydrogenase; computational analysis of large-scale protein-protein interaction data also suggests a role in fructose or mannose metabolism
Localization:
Intensity:
Fold change:
Significance:
-
C’ GFP library in SD

below threshold17.03 -
N' NOP1pr-GFP in SD

cytosol38.2689 -
N' TEF2pr-mCherry in SD

vacuole0 -
N' NATIVEpr-GFP in SD

below threshold19.3434 -
N' TEF2pr-VC and Cyto-VN in SD

#N/A0 -
C’ GFP library in SD+DTT

cytosol19.461.14No -
C’ GFP library in SD+H2O2

cytosol22.81.33No -
C’ GFP library in Starvation Media
cytosol38.992.28No -
C’ GFP library on the background of Pup2-DaMP

below threshold -
C’ GFP library on the background of CCT mutant

below threshold16.85690.989652No
